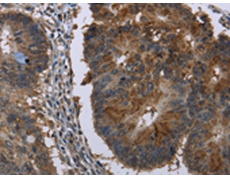
一抗

反應(yīng)種屬: Human, Mouse
標(biāo) 記 物: Unconjugate
克隆類型: rabbit polyclonal
技術(shù)規(guī)格
|
Background: |
The protein encoded by this gene has both oxidoreductase and epimerase activities and is involved in androgen catabolism. The oxidoreductase activity can convert 3 alpha-adiol to dihydrotestosterone, while the epimerase activity can convert androsterone to epi-androsterone. Both reactions use NAD+ as the preferred cofactor. This gene is a member of the retinol dehydrogenase family. |
|
Applications: |
ELISA, WB, IHC |
|
Name of antibody: |
HSD17B6 |
|
Immunogen: |
Fusion protein of human HSD17B6 |
|
Full name: |
hydroxysteroid (17-beta) dehydrogenase 6 |
|
Synonyms: |
HSE; RODH; SDR9C6 |
|
SwissProt: |
O14756 |
|
ELISA Recommended dilution: |
1000-2000 |
|
IHC positive control: |
Human colon cancer |
|
IHC Recommend dilution: |
25-100 |
|
WB Predicted band size: |
36 kDa |
|
WB Positive control: |
Mouse liver tissue |
|
WB Recommended dilution: |
200-1000 |




 購(gòu)物車
購(gòu)物車 幫助
幫助
 021-54845833/15800441009
021-54845833/15800441009